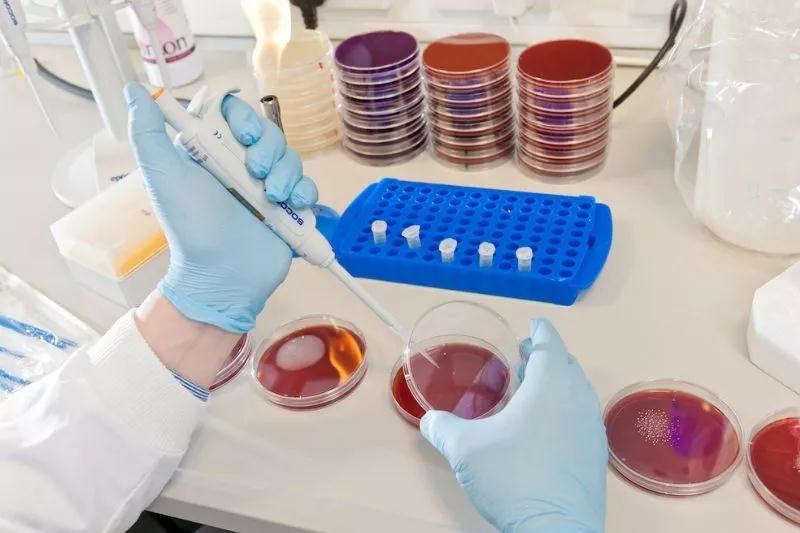

德勤公司发布的 《2019年全球生命科学展望报告》 中指出,全球药品支出在快速增长;从2018年到2024年, 药品的复合年增长率预计为6.4% ,是2011-2017年1.2%的六倍。同时由于医学科技日益昌明,很多罕见病的秘密都逐渐被掀开;到2024年, 罕见病用药行业预计将增速翻倍 。
同时,随着数字化继续塑造着制药行业的各个角落,新一代初创企业和科技巨头纷纷涌现,威胁着制药行业的传统文化。这一方面促进了 制药科技的不断创新发展 ,研究水平、精度和个性化都得到很大程度上的提高,另一方面也为制药行业的发展注入活力,促进了 行业内部的管理制度的转型和改革 。(资讯取材自前瞻网以及德勤报告)

随着经济和科技水平的不断发展,人们对健康的重视程度只会有增无减,这就意味着制药行业在未来必定是一片光明!在制药行业全球范围内,无论是科研开发,还是企业管理,都对人才有着巨大的需求。
因此为了培养新时代所需要的人才,Queen's精心打造了一门硕士课程:


课程模块解析
Queen's紧贴全球制药行业发展动态,并结合学院强大教研实力基础,设计出这个工业药剂学硕士课程。目的是为有志投身制药行业的学生们提供多方面的专业知识和技能,涵盖从开发、测试、生产以及质量保证等一系列药物开发阶段,帮助大家在制药行业多元化发展。
从课程模块可以看出,既有药物研发生产等的理工技术型教学,又有数据管理、领导力培养、以及行业洞悉等商务管理类培训。




广阔的发展空间
随着医药化工行业的不断兴起, 制药产业对高端药剂学人才的需求只增不减 !不论是制药业的研发、生产和监管领域,还是药物许可、卫生保健等政府监管机构都需要专业的药剂学人才来助阵。
经过多元综合的课程模块培养,工业药剂学毕业生不仅能掌握 制药相关的高端理论知识和新兴研发技术 ,还 熟悉医药企业的新药开发、审批和生产过程中的管理状况 ,成长为独当一面的 工业药剂研究员 ,拥有在全球制药领域中寻求职业发展的最强竞争力。
更多详情,请咨询佛山英爱部顾问老师。